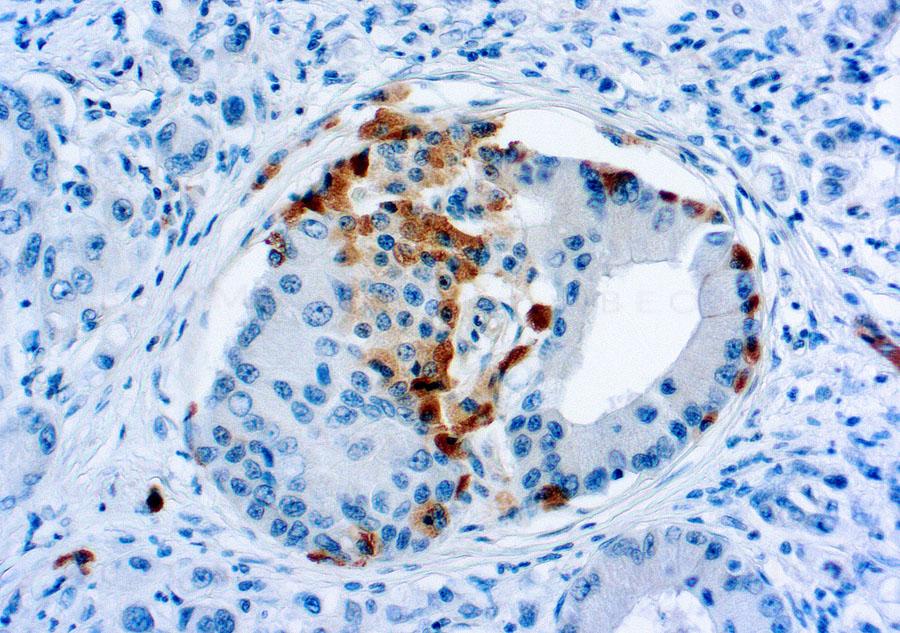

Rabbit Polyclonal Antibody to Somatostatin Receptor(Discontinued)
Figure 1 : Formalin fixed paraffin embedded human pancreas stained with Somatostatin Receptor antibody ( 10-11536).
Roll over image to zoom in

Shipping Info:
For estimated delivery dates, please contact us at [email protected]
Format : | Purified |
Amount : | 0.5 ml |
Isotype : | Rabbit IgG |
Content : | Purified immunoglobulin fraction of rabbit antiserum against human somatostatin receptor containing sodium azide as preservative. |
Storage condition : | Store at 2-8°C. |
Immunogen Information : | A synthetic peptide derived from the C-terminus of rat somatostatin protein. |
This antibody reacts with a 60 kDa protein, known as somatostatin receptor. Somatostatin family of receptors has five members, sst1-sst5, as well as two isoforms of somatostatin receptor 2, sst2A and sst2B. They are coupled to G protein and are involved in regulation of numerous processes including secretion of insulin, glucagons and growth hormone and excitation of neurons in central and peripheral nervous system.
IHC : 1:50-1:75
For Research Use Only. Not for use in diagnostic/therapeutics procedures.
There are currently no product reviews
|